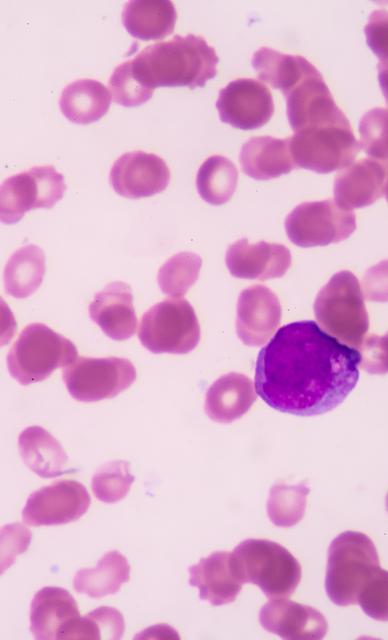
blood

Listen to our Medical Microbiology Podcast Episode
In Career Conversations, Dr Marilena Giannoudi discusses training and a career in Medical Microbiology with Dr Christopher Rooney.
Empowering medical excellence, shaping healthcare futures.
Author: Dr Niall Ahern, Registrar
Medical Microbiology is a broad and evolving specialty that spans all aspects of infection. Once largely laboratory-based with a focus on overseeing diagnostics, interpreting results, and advising clinicians, it has now become increasingly clinical and diverse.
The role now combines laboratory work with ward consultations for complex infections, infection-focused ward rounds, multidisciplinary meetings, and leadership in infection prevention and control across hospitals and the community. Microbiologists also play a key role in developing new services, such as OPAT (outpatient parenteral antibiotic therapy).
Medical Microbiology is a dynamic specialty, with new infections emerging and known pathogens constantly evolving. The specialty emphasises continual learning and development, offering a wide range of opportunities for research and service innovation. I particularly enjoy the multidisciplinary collaboration, as Medical Microbiologists work closely with a variety of hospital specialties to manage infections affecting all organ systems.
The combination of laboratory and clinical medicine adds variety to the role. Laboratory diagnostics enable infections to be accurately investigated and diagnosed from clinical samples, allowing tailored treatment plans for each patient. The increasingly clinical aspect of the specialty, including infection-focused ward rounds and outpatient antibiotic services, entails the provision of direct patient care.
I find Medical Microbiology especially rewarding, as most infections, unlike many other medical conditions, can be fully treated or suppressed. Guiding the investigation, diagnosis, and treatment of infection to effectively cure patients makes the specialty both professionally and personally fulfilling.
Involves conditions which affect any organ system
Close working relationship with a range of specialities
Most infections can be cured or effectively controlled
Diverse mix of both laboratory and clinical work
Flexible career pathways, including dual CCT with ID
Strong focus on research, teaching, and professional development
Not a lot of procedures
Less direct patient contact compared with some other specialties
Keeping up with constantly evolving antimicrobial guidelines across multiple body systems can be challenging
There is significant overlap with infectious diseases, and training has been restructured recently to reflect this. Most trainees now pursue a dual CCT in Medical Microbiology and Infectious Diseases (ID/MM), although a small number of programmes still offer a single CCT in Medical Microbiology (MM).
Medical Microbiology is a Group 2 specialty, whether or not it is paired with ID, with entry after two years of IMT or three years of ACCS-IM.
All trainees complete two years of Combined Infection Training, which includes clinical experience in an ID unit, infection outpatient clinics, microbiology and virology laboratory and clinical work, and infection consult rounds. This is followed by higher infection training: two years for MM alone or three years for ID/MM.
A limited number of posts are also available in Tropical Medicine paired with Medical Microbiology. Training includes around 12 months in a resource-poor tropical setting and at least 12 months at a UK Tropical Medicine Centre (Liverpool, London, or Birmingham).
FRCPath (2 parts) to be completed by ID/MM and MM trainees
Trainees are encouraged to take time out of programme, in the UK or overseas, to undertake research, teaching or leadership posts, or to gain clinical experience in different settings.
Arrange a taster session in Medical Microbiology.
Get involved in a QI project or audit related to infection.
Consider a clinical fellow post in an infection related specialty.

09:00 – 10:00 | Handover
Review out-of-hours advice calls and follow up on complex infection cases.
10:00 – 11:00 | Laboratory Bench Round
Collect new results and review clinical specimens in the laboratory. Liaise with the biomedical scientist team to discuss unexpected results or lab issues.
11:00 – 13:00 | Result Communication
Communicate urgent results to clinical teams, providing guidance on infection management.
13:00 – 14:00 | ICU Ward Round
Join the ICU team to advise on the management of infections in critically ill patients.
14:00 – 15:00 | Infection Control / Outbreak Meeting
Meet with infection control nurses to address hospital infection control issues or provide guidance during outbreaks.
14:00 – 17:00 | Clinical Telephone Advice
Provide advice to clinicians on the investigation, diagnosis and management of infections.
In Career Conversations, Dr Marilena Giannoudi discusses training and a career in Medical Microbiology with Dr Christopher Rooney.